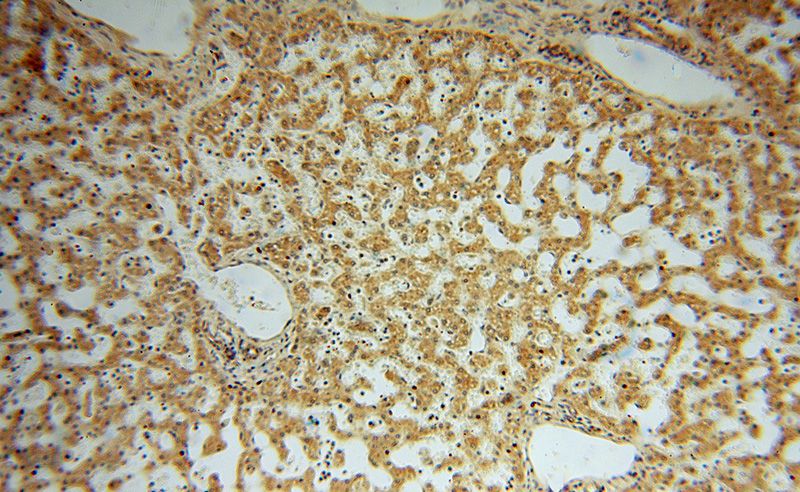
Immunohistochemical of paraffin-embedded human liver using Catalog No:110790(FUCA1 antibody) at dilution of 1:50 (under 10x lens)

-
Product Name
FUCA1 antibody
- Documents
-
Description
FUCA1 Rabbit Polyclonal antibody. Positive IHC detected in human liver tissue, human heart tissue, human kidney tissue, human liver cancer tissue, human placenta tissue, human testis tissue.
-
Tested applications
ELISA, IHC
-
Species reactivity
Human,Mouse,Rat; other species not tested.
-
Alternative names
Alpha L fucosidase 1 antibody; Alpha L fucosidase I antibody; FUCA antibody; FUCA1 antibody; fucosidase antibody; alpha L 1 antibody; tissue antibody; Tissue alpha L fucosidase antibody
-
Isotype
Rabbit IgG
-
Preparation
This antibody was obtained by immunization of FUCA1 recombinant protein (Accession Number: BC017338). Purification method: Antigen affinity purified.
-
Clonality
Polyclonal
-
Formulation
PBS with 0.02% sodium azide and 50% glycerol pH 7.3.
-
Storage instructions
Store at -20℃. DO NOT ALIQUOT
-
Applications
Recommended Dilution:
IHC: 1:20-1:200
-
Validations
Immunohistochemical of paraffin-embedded human liver using Catalog No:110790(FUCA1 antibody) at dilution of 1:50 (under 10x lens)

Immunohistochemical of paraffin-embedded human liver using Catalog No:110790(FUCA1 antibody) at dilution of 1:50 (under 40x lens)
-
Background
FUCA1(a-l-Fucosidase) is a lysosomal glycosidase which is ubiquitous in eukaryotic cells. This enzyme is usually found as a soluble component of the lysosome and functions as an acid hydrolase in the degradation of numerous and diverse fucoglycoconjugates.The mammalian a-l-fucosidases are relatively large, multisubunit glycoproteins which exist in multiple molecular isoforms.This enzyme may have a role in sperm-egg interactions in the reproductive tract of the female rat. There is a precursor 54 kDa form of rat sperm fucosidase which is processed to a mature 52 kDa form of the enzyme(PMID:8836125). This protein from rat epididymis is a tetramer of 210-220 kDa, made up by two pairs of subunits of 47 and 60 kDa, and the one from human seminal plasma exists in different oligomeric forms, that is, as a dimer, as a tetramer, and as a hexamer made up of a single subunit of 56-57 kDa(PMID:16736526).
Related Products / Services
Please note: All products are "FOR RESEARCH USE ONLY AND ARE NOT INTENDED FOR DIAGNOSTIC OR THERAPEUTIC USE"
